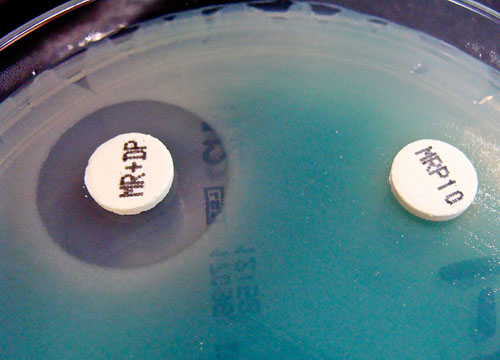

world health organization
WHO Highlights Hand Washing Need
Good hand hygiene practices among healthcare practitioners could halt the spread of antibiotic-resistant bacteria, says WHO.
WHO Report Highlights Antibiotic Resistance Threat
The first WHO report on antibiotic resistance provides a comprehensive picture of the problem to date, with data from 114 countries.
WHO Issues First Hepatitis C Guidelines
The recommendations include increasing hepatitis C screening, liver damage mitigation and how to select appropriate treatment for chronic infections.
Small Bite, Big Threat
Mosquitoes, flies, ticks and bugs may be a threat to your health and that of your family, warns the World Health Organization.
WHO Declares Southeast Asia Polio-Free
After three years of zero polio cases, the World Health Organization has certified that Southeast Asia is polio-free.
Indonesia Held Back By Neglected Tropical Diseases
Local scientists say that their research should be incorporated into plans to combat neglected tropical diseases in Indonesia.
Mystery Kidney Disease Spreads In Sri Lanka
Scientists have been unable to determine the cause of a kidney disease which mainly affects farmers over 40.
India Needs Climate-Resilient Sanitation Tech
India needs to integrate climate-resilient sanitation technologies with relevant national policies, says Girija K. Bharat.
Drug-Resistant Malaria Gaining Ground In SE Asia
Although malaria deaths and diagnoses have declined, a worrying drug-resistance is emerging in Southeast Asia.